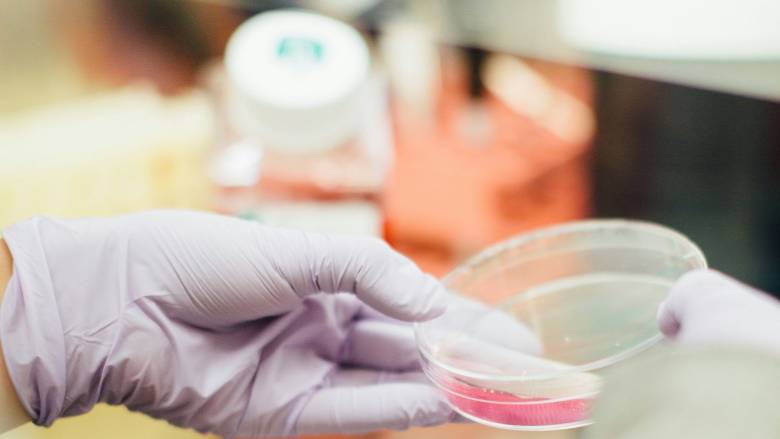
Ιάπωνας επιστήμονας ζήλεψε την προαγωγή συναδέλφου του και του έβαλε... τοξικές ουσίες στο νερό

Ιάπωνας επιστήμονας ζήλεψε την προαγωγή συναδέλφου του και του έβαλε... τοξικές ουσίες στο νερό
Κατηγορίες σε βάρος Ιάπωνα επιστήμονα που έριξε χημικές ουσίες στο μπουκάλι με νερό του Αμερικανού συναδέλφου του, απήγγειλαν οι εισαγγελικές Αρχές στο Ουισκόνσιν των ΗΠΑ.
Ο Αμερικανός ερευνητής είχε καλέσει την αστυνομία αφού παρατήρησε μια ασυνήθιστη μυρωδιά που έμοιαζε με χημική ουσία στο μπουκάλι νερού που είχε αφήσει στο εργαστήριο, καθώς και στα παπούτσια του. Έφτυσε αμέσως το νερό και δεν υπήρξαν αρνητικές επιπτώσεις στην υγεία του, σύμφωνα με το Japan Times.
Οι Αρχές συνέλαβαν στις 10 Απριλίου τον 41χρονο Μακότο Κουρόντα, ο οποίος παραδέχθηκε ότι ζήλεψε την... προαγωγή του συναδέλφου του και ήθελε να τον βλάψει.
Αποκάλυψε, δε, ότι πρόσθεσε χημικές ουσίες που βρισκόταν στο εργαστήριο, συμπεριλαμβανομένης της τοξικής ουσίας παραφορμαλδεΰδης στο νερό και τα παπούτσια.
Οι Αρχές του απήγγειλαν δίωξη για απόπειρα σωματικής βλάβης μεταξύ άλλων.

«Φαρμακείο αυτοκινήτου»: Νέο κιτ πρώτων βοηθειών - Τι πρέπει να περιλαμβάνει
02:00
Πότε αναμένεται να καταβληθεί η έκτακτη οικονομική ενίσχυση των 150 ευρώ ανά παιδί
01:00
Ανακαίνιση Κατοικίας: Πότε ξεκινούν οι αιτήσεις για τις βεβαιώσεις επιλεξιμότητας
00:30
Πρόταση για την αναγνώριση της γενοκτονίας των Αρμενίων θα φέρει το ισραηλινό ΥΠΕΞ
23:57








